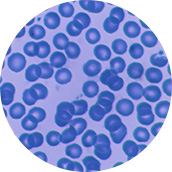
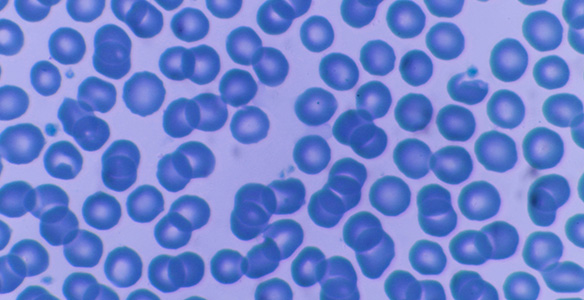

Healthcare and Life Science
Aiming to raise people's quality of life, the DNP Group develops and provides products and services that support a healthy life.
Three points
Application of microfabrication technology to regenerative medicine

Provision of packages with barrier films

Fusion of printing technology and information technology
The DNP Group is developing new business fields in the life science sector by adding new technologies, including biotechnology, to the basic technology of its printing business and derived technologies. By doing so, the Group will help to improve people’s quality of life (QOL) and help them live each day to the fullest.
Point1Application of microfabrication technology to regenerative medicine
By creating special containers with a microfabricated surface, the Group has made it possible to produce various cell sheets at the cell level.
Point2Provision of packages with barrier films
The DNP Group provides safe and hygienic packages with barrier films utilizing deposition technology for foods, beverages, daily necessities and medical products.


Point3Fusion of printing technology and information technology
The DNP Group is developing advanced products and image processing systems.
Details
- The DNP Group has responded to demand in the regenerative medicine field for cell sheets that can be peeled off from a Petri dish while keeping their shape intact. This is made possible by applying microfabrication technology from the printing field on the surface of containers.
- Regenerative medicine is now approaching practical application. In addition to providing medical materials, the Group is also developing information processing technologies including color management and three-dimensional image processing, looking to continue cultivating new processes behind the scenes.
- Awareness of a "healthy life span" is increasing, and preventive medicine is important for prolonging a heathy life. The Group is aiming to develop a personal health management system as its next business area.
- Utilizing its strengths in image processing technologies, the Group is developing a fisheye surveillance camera that corrects image distortion, as well as image analysis technology that can help link MRI images of eyeballs to possible disease causes.
We welcome detailed material requests and inquiries regarding the solutions introduced on this page.
Please do not hesitate to contact us with any comments or requests.